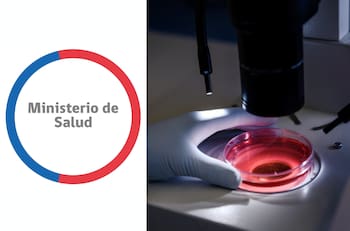
Minsal emite alerta alimentaria por presencia de bacteria en cuatro productos

El pasado 24 de diciembre el Minsal había decretado la medida solo para la Región Metropolitana, pero ahora se extendió a otras zonas del país.
Siete regiones se encuentran bajo alerta alimentaria por brote de listeria detectado en queso de cabeza
Esta bacteria puede provocar síntomas como fiebre, dolores musculares y, en casos graves, complicaciones en el sistema nervioso.
SEREMI de salud emite alerta alimentaria por quesillo infectado con Listeria
El organismo solicitó a los comercios el retiro de los alimentos contaminados.
Minsal emite alerta alimentaria por presencia de bacteria en cuatro productos
Se trata de los productos Elecare y Simalac del Laboratorio Abott los que han sido retirados del mercado luego de recibir una serie de quejas relacionadas a la aparición de bacterias en lactantes menores de 12 meses.
Alerta alimentaria preventiva para lactantes: estos son los productos y lotes que llamaron a "no consumir"
Los productos destinados a niños menores de un año podrían contener Cronobacter Sakazakii o Salmonella Newport, lo que puede generar cuadros gastrointestinales, bacteriemia, meningitis y enterocolitis necrotizante.